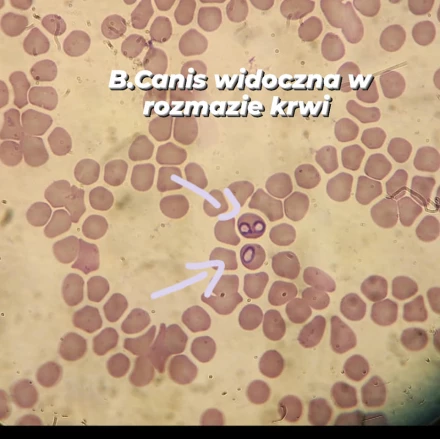

Laboratorium
Regularne wizyty kontrolne u lekarza weterynarii, wraz z wykonaniem zaleconych badań, są kluczowe dla wczesnego wykrywania i leczenia potencjalnych problemów zdrowotnych u naszych pupili; dlatego nie zwlekaj i umów wizytę już dziś, aby zadbać o zdrowie swojego zwierzaka.
Oferujemy kompleksowe usługi laboratoryjne, które są kluczowe dla diagnozowania i leczenia Twojego pupila. Dzięki nowoczesnemu wyposażeniu oraz współpracy z renomowanymi zewnętrznymi laboratoriami, zapewniamy szeroki wachlarz badań laboratoryjnych, które wykonujemy z najwyższą precyzją i dbałością o każdy szczegół.
Badania krwi
Szczegółowe analizy pozwalają nam dokładnie ocenić stan zdrowia naszych pacjentów. Dzięki zaawansowanemu sprzętowi i odczynnikom firmy IDEXX i VCheck (Vetexpert), zapewniamy precyzyjne i szybkie wyniki. Niewątpliwą zaletą jest możliwość wykonania badań w weekend oraz w sytuacjach nagłych podczas wizyty, dzięki czemu jesteśmy w stanie jak najszybciej wdrożyć odpowiednie leczenie. Oferujemy rozszerzoną morfologię (wraz z retikulocytami umożliwiającymi ocenę stopnia regeneracji w przypadku anemii), szereg paneli biochemicznych oraz pojedynczych analiz takich jak: CRP, cPL, fPL, progesteron, T4.
.jpg)
Badanie moczu
Wykonujemy badanie fizyko-chemiczne oraz badanie osadu moczu. Regularne badanie moczu jest ważne dla zdrowia zwierząt, ponieważ pozwala na wczesne wykrycie wielu schorzeń. Dzięki badaniu moczu możemy ocenić funkcje nerek i układu moczowego, co pozwala na wczesne wykrycie chorób nerek oraz infekcji dróg moczowych. Ponadto, badanie moczu umożliwia diagnozowanie cukrzycy, monitorowanie zdrowia metabolicznego i wykrywanie obecności kryształów, które mogą prowadzić do powstawania kamieni moczowych. Analiza moczu może również pomóc w wykryciu nowotworów pęcherza moczowego oraz ocenie stanu nawodnienia organizmu. Regularne badanie moczu jest kluczowe dla utrzymania zdrowia Twojego pupila, pozwalając na wczesne wykrycie i skuteczne leczenie wielu schorzeń.
.jpg)
.jpg)
Diagnostyka chorób pasożytniczych
Choroby pasożytnicze są powszechnym problemem zdrowotnym u psów i kotów. Pasożyty mogą atakować różne układy organizmu, w tym skórę, przewód pokarmowy, układ oddechowy i krwionośny. Do najczęściej spotykanych pasożytów należą pchły, kleszcze, roztocza, nicienie, tasiemce oraz pierwotniaki. Regularne badania i profilaktyka, w tym stosowanie odpowiednich preparatów przeciwpasożytniczych, są kluczowe dla utrzymania zdrowia Twojego zwierzaka. Wczesne wykrycie i leczenie chorób pasożytniczych pozwala na uniknięcie poważnych komplikacji zdrowotnych. Oferujemy:
- Diagnostykę mikroskopową i serologiczną chorób pasożytniczych krwi: Wykonujemy rozmazy krwi w kierunku chorób pasożytniczych krwi, a także szybkie testy diagnostyczne, które pozwalają na natychmiastowe wykrycie chorób zakaźnych u psów i kotów.
- Badanie zeskrobin ze skóry: badanie umożliwia stwierdzenie obecności nużeńca, świerzbu czy innych ektopasożytów w badanej próbce.
- Badanie kału: Przeprowadzamy badania kału, co jest kluczowe w diagnostyce pasożytów jelitowych.

Określenie momentu najlepszego krycia suki
Oznaczamy poziom progesteronu w surowicy krwi oraz oceniamy wymaz z pochwy, co umożliwia precyzyjne określenie optymalnego czasu na krycie.
Ocena materiału ze zmian rozrostowych
Przeprowadzamy badania cytologiczne materiału pobranego metodą biopsji aspiracyjnej cienkoigłowej i gruboigłowej, co pozwala na dokładną diagnozę zmian nowotworowych i innych patologii.
Inne badania mikroskopowe
Cytologia płynów ustrojowych, wymazu ze zmian skórnych oraz z ucha: Dzięki szczegółowym badaniom cytologicznym możemy szybko i skutecznie wykryć stan patologiczny i wdrożyć odpowiednie leczenie.
Dzięki współpracy z wieloma zewnętrznymi laboratoriami, jesteśmy w stanie zaoferować także specjalistyczne testy, które są niedostępne na miejscu. Nasz zespół zapewni profesjonalne podejście do każdego badania, co gwarantuje wiarygodne i szybkie wyniki.




.jpg)